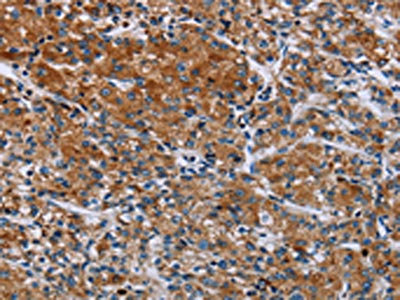

HYAL3 Antibody
-
中文名稱:HYAL3兔多克隆抗體
-
貨號:CSB-PA928714
-
規(guī)格:¥1100
-
圖片:
-
The image on the left is immunohistochemistry of paraffin-embedded Human cervical cancer tissue using CSB-PA928714(HYAL3 Antibody) at dilution 1/40, on the right is treated with fusion protein. (Original magnification: ×200)
-
The image on the left is immunohistochemistry of paraffin-embedded Human prostate cancer tissue using CSB-PA928714(HYAL3 Antibody) at dilution 1/40, on the right is treated with fusion protein. (Original magnification: ×200)
-
Gel: 8%SDS-PAGE, Lysate: 40 μg, Lane: Human kidney tissue, Primary antibody: CSB-PA928714(HYAL3 Antibody) at dilution 1/400, Secondary antibody: Goat anti rabbit IgG at 1/8000 dilution, Exposure time: 3 minutes
-
-
其他:
產(chǎn)品詳情
-
Uniprot No.:
-
基因名:HYAL3
-
別名:Hyal-3 antibody; HYAL3 antibody; HYAL3_HUMAN antibody; Hyaluronidase 3 antibody; Hyaluronidase-3 antibody; Hyaluronoglucosaminidase 3 antibody; Hyaluronoglucosaminidase-3 antibody; LUCA-3 antibody; LUCA14 antibody; LUCA3 antibody; Lung carcinoma protein 3 antibody; Minna14 antibody
-
宿主:Rabbit
-
反應(yīng)種屬:Human,Rat
-
免疫原:Fusion protein of Human HYAL3
-
免疫原種屬:Homo sapiens (Human)
-
標(biāo)記方式:Non-conjugated
-
抗體亞型:IgG
-
純化方式:Antigen affinity purification
-
濃度:It differs from different batches. Please contact us to confirm it.
-
保存緩沖液:-20°C, pH7.4 PBS, 0.05% NaN3, 40% Glycerol
-
產(chǎn)品提供形式:Liquid
-
應(yīng)用范圍:ELISA,WB,IHC
-
推薦稀釋比:
Application Recommended Dilution ELISA 1:2000-1:5000 WB 1:500-1:2000 IHC 1:50-1:200 -
Protocols:
-
儲存條件:Upon receipt, store at -20°C or -80°C. Avoid repeated freeze.
-
貨期:Basically, we can dispatch the products out in 1-3 working days after receiving your orders. Delivery time maybe differs from different purchasing way or location, please kindly consult your local distributors for specific delivery time.
-
用途:For Research Use Only. Not for use in diagnostic or therapeutic procedures.
相關(guān)產(chǎn)品
靶點詳情
-
功能:Facilitates sperm penetration into the layer of cumulus cells surrounding the egg by digesting hyaluronic acid. Involved in induction of the acrosome reaction in the sperm. Involved in follicular atresia, the breakdown of immature ovarian follicles that are not selected to ovulate. Induces ovarian granulosa cell apoptosis, possibly via apoptotic signaling pathway involving CASP8 and CASP3 activation, and poly(ADP-ribose) polymerase (PARP) cleavage. Has no hyaluronidase activity in embryonic fibroblasts in vitro. Has no hyaluronidase activity in granulosa cells in vitro.
-
基因功能參考文獻(xiàn):
- the relative expression of hyalurosome (CD44, HAS3, HB-EGF) genes was found to be reduced in patients prior to topical treatment and to be notably increased following treatment. PMID: 25138066
- mutations of the HYAL3 gene are rare in Chinese lung squamous cell carcinoma patients and might contribute to lymph node metastasis PMID: 23549009
- polymorphisms in HYAL3 are potentially involved in glaucomatous neurodegeneration. PMID: 22960332
- Nodular basal cell carcinoma is associated with increased levels of hyaluronic acid concomitant with upregulation of gene expression of HAS3, HYAL3 and RHAMM, when compared with normal adjacent skin. PMID: 20849445
- Overexpression of HYAL3 is associated with colorectal cancer. PMID: 20849597
- Hyal3 null sperm showed delayed cumulus penetration and reduced acrosomal exocytosis. PMID: 20586096
- Characterization of the murine hyaluronidase gene region reveals complex organization and cotranscription of Hyal1 with downstream genes, Fus2 and Hyal3. PMID: 11929860
- Alternative mRNA splicing controls cellular expression of enzymatically active hyaluronidase. PMID: 12084718
- Down-regulation of HYAL3 is associated with small cell lung cancer and glioma PMID: 12684632
顯示更多
收起更多
-
亞細(xì)胞定位:Secreted. Cell membrane. Cytoplasmic vesicle, secretory vesicle, acrosome. Endoplasmic reticulum. Early endosome.
-
蛋白家族:Glycosyl hydrolase 56 family
-
組織特異性:Expressed in sperm. Highly expressed in epidermis of the skin, where it is expressed intracellularily in the deep horny layer (at protein level). Bone marrow, testis and kidney.
-
數(shù)據(jù)庫鏈接:
Most popular with customers
-
-
YWHAB Recombinant Monoclonal Antibody
Applications: ELISA, WB, IHC, IF, FC
Species Reactivity: Human, Mouse, Rat
-
-
-
-
-
-